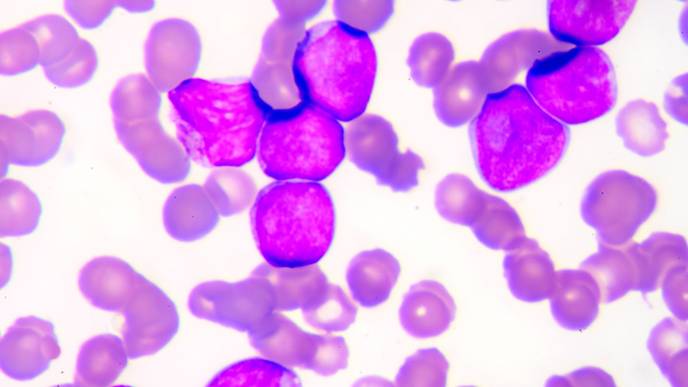
ReachMD Healthcare Image

Obesity Linked to Detection of Blood Cancer Precursor
Individuals with obesity are more likely to have monoclonal gammopathy of undetermined significance (MGUS), a benign blood condition that often precedes multiple myeloma, according to new research published in Blood Advances.
Multiple myeloma is a blood cancer of the plasma cells, a type of white blood cells that produce antibodies to fight infection. MGUS, characterized by an abnormal protein produced by plasma cells, is a known precursor to multiple myeloma.
Most people with MGUS exhibit no significant symptoms and are not immediately ill. Rather, the presence of MGUS serves as a warning to monitor for the potential development of more critical conditions, like multiple myeloma, that MGUS can turn into.
The Centers for Disease Control and Prevention reported in 2020 that nearly 42% of the US population is classified as obese, defined by a body mass index (BMI) of 30 or higher. Yet, little research exists to suggest how obesity may impact cancer outcomes.
"While significant advancements have been made in therapeutics for multiple myeloma, it remains an incurable disease, often diagnosed after patients have already experienced end-organ damage," explained David Lee, MD, MPH, MMSc, an internal medicine resident at Massachusetts General Hospital.
"It's preceded by premalignant conditions including MGUS. Our research group is focused on investigating risk factors and etiology of MGUS to better understand who may be at increased risk for developing MGUS and its progression to multiple myeloma."
Investigators enrolled 2,628 individuals from across the United States who were at elevated risk of developing multiple myeloma, based on self-identified race and family history of hematologic malignancies, between February 2019 and March 2022.
Participants were screened for MGUS, defined by the presence of monoclonal proteins at serum concentrations of 0.2g/L or greater. Investigators measured MGUS using mass spectrometry—a novel, highly sensitive method of identifying and quantifying monoclonal proteins in the blood.
After controlling for age, sex, race, education, and income, the team found that being obese was associated with 73% higher odds of having MGUS, compared to individuals with normal weights. This association remained unchanged when accounting for physical activity.
However, highly active individuals (defined as doing the equivalent of running or jogging 45–60 minutes per day or more) were less likely to have MGUS even after adjusting for BMI class, whereas those who reported heavy smoking and short sleep were more likely to also have detectable levels of MGUS.
Limitations include that this was a cross-sectional study—a snapshot of how certain variables or characteristics may relate to one another at a single point in time. While investigators found a strong correlation between MGUS, obesity, and lifestyle factors, they do not have enough evidence to assume causation.
Additionally, the American Medical Association recently voted to adopt a new policy that no longer uses BMI alone to assess whether someone is of a healthy weight, as previous research suggests the metric does not effectively distinguish between fat and lean mass and does not account for how fat is distributed throughout the body. The formula was created based on data from non-Hispanic white populations, suggesting its implications cannot accurately be generalized across Black, Asian, and Hispanic groups.
Going forward, researchers will aim to validate these findings in other study cohorts, including individuals who are followed longitudinally, to further explore the mechanisms through which obesity and other modifiable risk factors might influence the development and progression of MGUS.
"These results guide our future research in understanding the influence of modifiable risk factors, such as weight, exercise, and smoking, on cancer risk," explained Dr. Lee. "Before we can develop effective preventative health strategies to lower the risk of serious diseases like multiple myeloma, we first need to better understand the relationship between MGUS and potentially modifiable risk factors like obesity."
Citation: Obesity linked to detection of blood cancer precursor (2024, January 12) retrieved 12 January 2024 from https://medicalxpress.com/news/2024-01-obesity-linked-blood-cancer-precursor.html
This document is subject to copyright. Apart from any fair dealing for the purpose of private study or research, no part may be reproduced without the written permission. The content is provided for information purposes only.